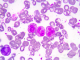
Targeted elimination of leukemic stem cells

Trending Now
Gender bias in POTS diagnosis reveals hidden impact
New research by the University of Adelaide has found it takes nearly twice as long for women to receive a Postural Orthostatic Tachycardia Syndrome (POTS) diagnosis when compared to men.
University of Manchester ranks in top 5 universities for spinout generation
The University of Manchester has been ranked the fourth highest academic institution for the total number of spinout companies generated in the Spotlight on Spinouts 2025 report.
UWA launches first Doctor of Pharmacy Practice
The University of Western Australia is set to offer Australia's first Doctor of Pharmacy Practice, a pioneering one-year online program designed...
SPONSOR
Recruitment | Welcome to Join the International Recruitment Team of Queen’s University, United Kingdom
Queen’s University Belfast is currently searching for a dynamic professional to join our team in China as the Business Development Manager.
Job Title: Senior Recruitment Officer for China
Job Title: Senior Recruitment Officer for China
Salary: Competitive salary package with performance bonus
Contract: Full-Time, fixed term 3 years in the first instance with the possibility of extension
Location: Beijing or Shanghai
How to find a job on LinkedIn?
Learn how to use LinkedIn to find the job you want! Discover how to build your network and advance your career.
UM’s online Career and Internship Fair provides over 3,000 job vacancies
The University of Macau (UM) kicked off its online Career and Internship Fair. Approximately 110 companies and organisations participated in this year’s fair, providing over 3,000 job vacancies.
International recognition for Highly Cited Researchers
More than 20 University of Adelaide researchers have been recognised for their outstanding work in the Clarivate annual global list of Highly Cited Researchers (HCR).